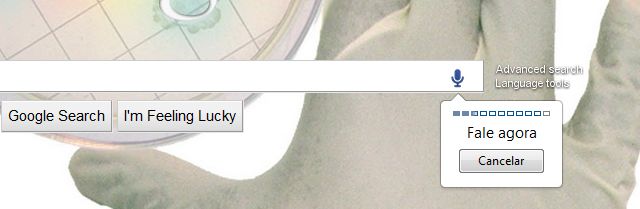

Com a capacidade do Google Chrome 11 em oferecer suporte a uma API de entrada de voz (HTML5), o navegador do Google agora é capaz de lidar com aplicativos para web que trabalhem na transcrição de voz para texto.
“O áudio é gravado e enviado aos servidores para a transcrição da fala, o texto então é digitado para você”, explicou Sampath Satish, Engenheiro de Software, no blog oficial da companhia.
Enquanto Mountain View trabalha em uma solução própria (acreditamos nisso!), um desenvolvedor apresentou hoje na Chrome Web Store um aplicativo gratuito que traz a funcionalidade de pesquisa por voz e pode ser testada de forma imediata.
“Você já desejou poder fazer uma pesquisa tão rápida quanto dizer Google? Agora você pode! Você pode usar o recurso em em outros sites como Hulu, Amazon, YouTube, e muito mais”, descreve a extensão que funciona somente no Google Chrome 11 beta ou dev.
✨ Curtiu este conteúdo?
O GDiscovery está aqui todos os dias trazendo informações confiáveis e independentes sobre o universo Google - e isso só é possível com o apoio de pessoas como você. 🙌
Com apenas R$ 5 por mês, você ajuda a manter este trabalho no ar e leva informação de qualidade para ainda mais gente!
Estou testando mas até agora não entendeu o português, só em inglês
Em nossos testes o recurso funcionou normalmente em português. Veja que você precisa falar em alto e bom som e preferencialmente em ambientes sem ruído.
só funciona na C.N.T.P ? kkkkkkkkk
kkkkkkkk
n tem o botão do microfone la, man =/
Bom dia! Quero compatilhar com vocês mais uma nova ferramenta do Google, o Google Apps Marketplace. Poderiam publicar algo sobre? Obrigado e parabnes pelo excelente trabalho!
Olá Roberto, nós temos um post sobre o Apps Marketplace. Você pode localizar através do sistema de pesquisa interno. Abs!
É disso que eu to falando, muito show mesmo. Vamos esperar pra fazer alguntes da nova funçao.
Valeu!
Assim, o Feed Burner também sofre mudanças no layout!
Já existia uma extensão que fazia a mesma coisa porém não conseguia testar por falta de microfone. Entretanto parace está bem mais assistido pela nova versão do Chrome dev.
Muito legal. Curioso, mas parece que o sistema entende melhor quando a frequencia da voz não é tão grave. Achei muito bacana.
Muito interessante, fiz o teste e funcionou perfeitamente. Como a amiga acima, tive que atualizar a versão.
Valeu pela dica.
Deve ser bom pra quem conseguiu baixa no meu xperia mini10x naum deu serto ainda
Eu gostei, gente só queria informar que é Certo com c nao com S
cd o microoo?????????